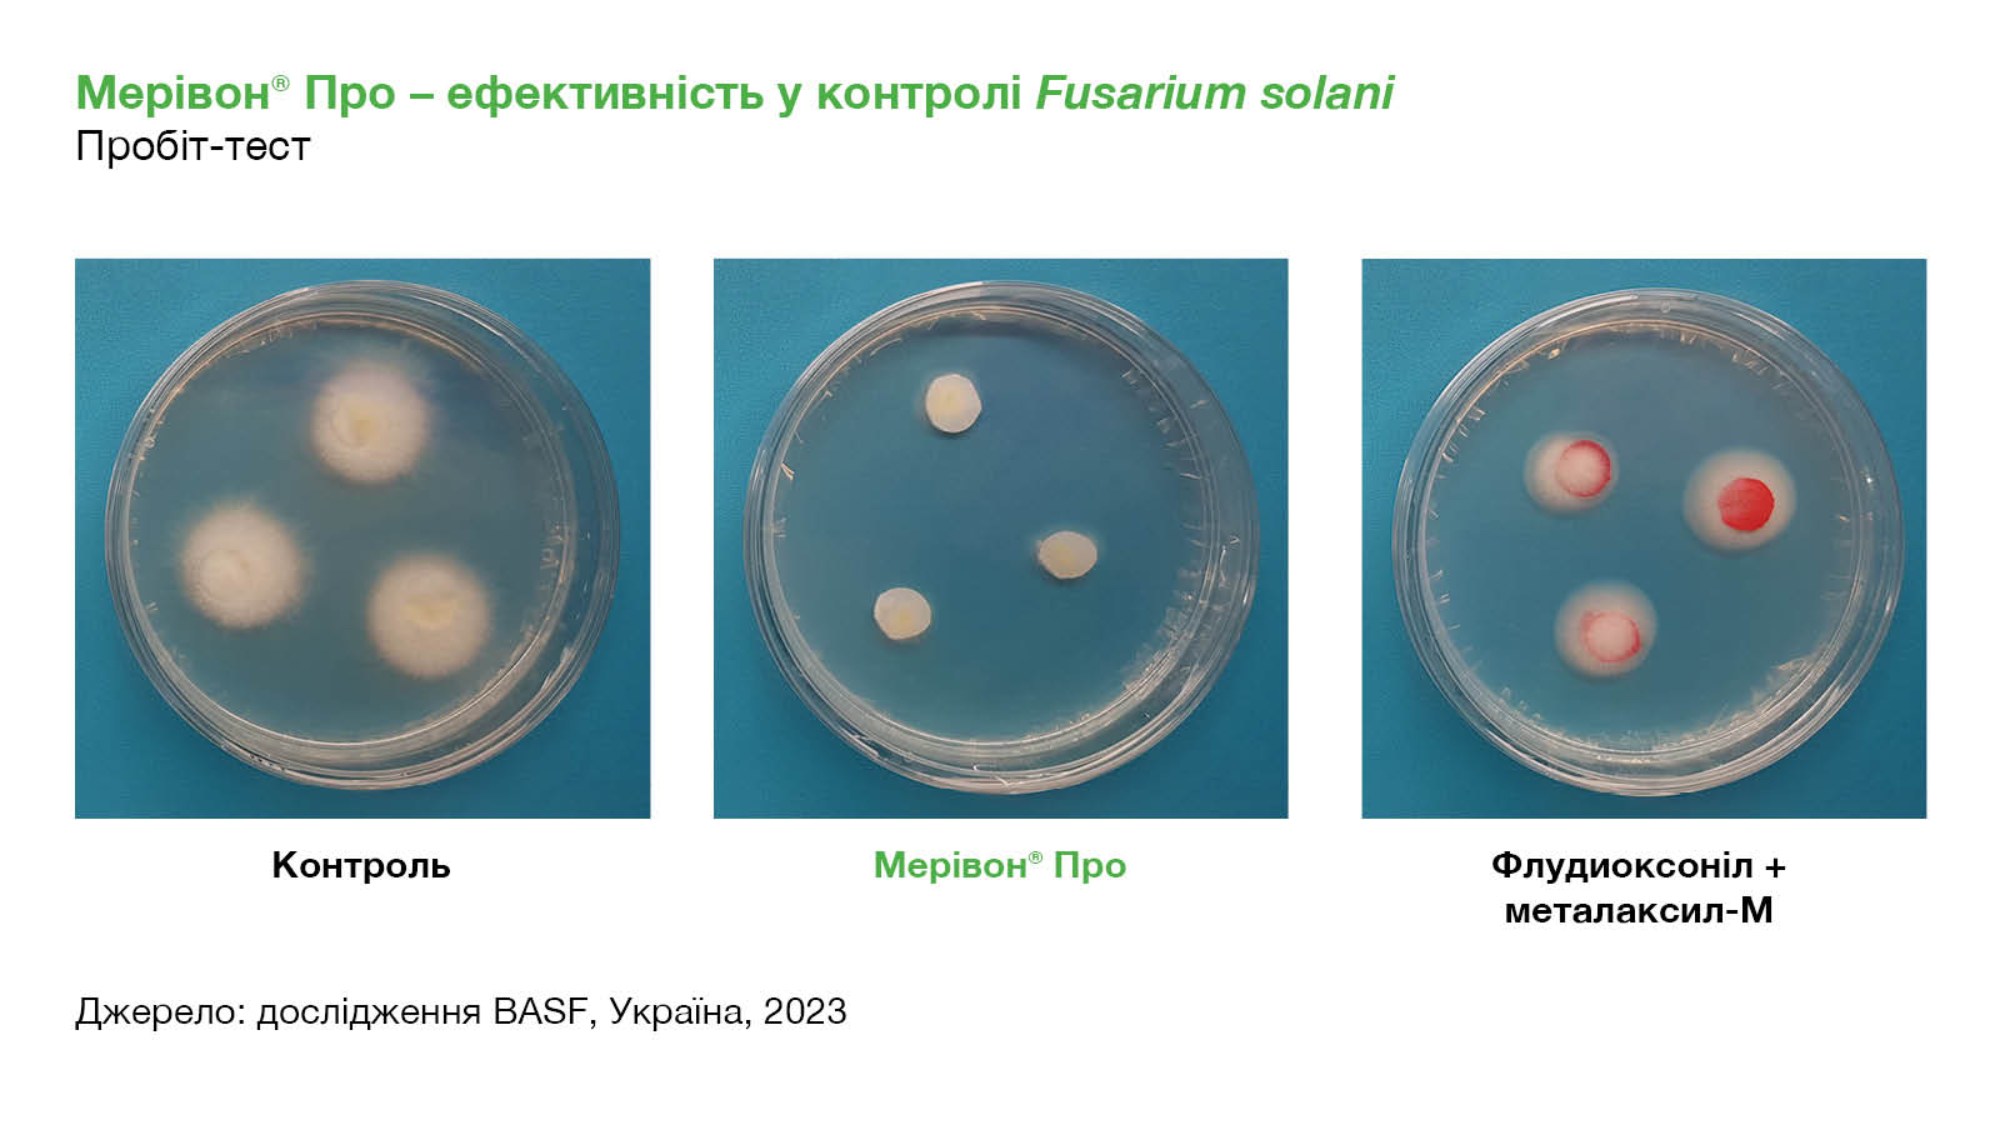

Мерівон® Про
Перший протруйник для сої,що містить Ксеміум®.
Мерівон® Про
Перший протруйник для сої,що містить Ксеміум®.
Переваги препарату
- Ефективний контроль широкого спектру хвороб насіння і сходів сої, завдяки поєднанню перевіреної ефективності піраклостробіна і інноваційної потужності Ксеміум®.
- Преміальний захист від ключових хвороб за доступною ціною
- Позитивний вплив на польову схожість і ростові процеси рослин сої
- Сумісний з інокулянтами
Документи
| Паспорт безпечності | |
|---|---|
| Брошура |